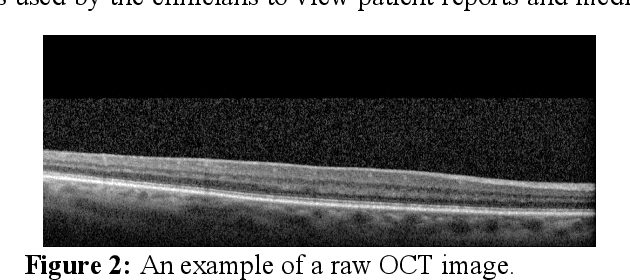
Figure 3 for Efficient OCT Image Segmentation Using Neural Architecture Search

Abstract:The clinical deployment of deep learning models for high-stakes tasks such as diabetic retinopathy (DR) grading requires demonstrable reliability. While models achieve high accuracy, their clinical utility is limited by a lack of robust uncertainty quantification. Conformal prediction (CP) offers a distribution-free framework to generate prediction sets with statistical guarantees of coverage. However, the interaction between standard training practices like data augmentation and the validity of these guarantees is not well understood. In this study, we systematically investigate how different data augmentation strategies affect the performance of conformal predictors for DR grading. Using the DDR dataset, we evaluate two backbone architectures -- ResNet-50 and a Co-Scale Conv-Attentional Transformer (CoaT) -- trained under five augmentation regimes: no augmentation, standard geometric transforms, CLAHE, Mixup, and CutMix. We analyze the downstream effects on conformal metrics, including empirical coverage, average prediction set size, and correct efficiency. Our results demonstrate that sample-mixing strategies like Mixup and CutMix not only improve predictive accuracy but also yield more reliable and efficient uncertainty estimates. Conversely, methods like CLAHE can negatively impact model certainty. These findings highlight the need to co-design augmentation strategies with downstream uncertainty quantification in mind to build genuinely trustworthy AI systems for medical imaging.
Abstract:Vision-Language Models (VLMs) have achieved remarkable success on multimodal tasks such as image-text retrieval and zero-shot classification, yet they can exhibit demographic biases even when explicit protected attributes are absent during training. In this work, we focus on automated glaucoma screening from retinal fundus images, a critical application given that glaucoma is a leading cause of irreversible blindness and disproportionately affects underserved populations. Building on a reweighting-based contrastive learning framework, we introduce an attribute-agnostic debiasing method that (i) infers proxy subgroups via unsupervised clustering of image-image embeddings, (ii) computes gradient-similarity weights between the CLIP-style multimodal loss and a SimCLR-style image-pair contrastive loss, and (iii) applies these weights in a joint, top-$k$ weighted objective to upweight underperforming clusters. This label-free approach adaptively targets the hardest examples, thereby reducing subgroup disparities. We evaluate our method on the Harvard FairVLMed glaucoma subset, reporting Equalized Odds Distance (EOD), Equalized Subgroup AUC (ES AUC), and Groupwise AUC to demonstrate equitable performance across inferred demographic subgroups.




Abstract:Gastrointestinal (GI) endoscopy is essential in identifying GI tract abnormalities in order to detect diseases in their early stages and improve patient outcomes. Although deep learning has shown success in supporting GI diagnostics and decision-making, these models require curated datasets with labels that are expensive to acquire. Foundation models offer a promising solution by learning general-purpose representations, which can be finetuned for specific tasks, overcoming data scarcity. Developing foundation models for medical imaging holds significant potential, but the sensitive and protected nature of medical data presents unique challenges. Foundation model training typically requires extensive datasets, and while hospitals generate large volumes of data, privacy restrictions prevent direct data sharing, making foundation model training infeasible in most scenarios. In this work, we propose a FL framework for training foundation models for gastroendoscopy imaging, enabling data to remain within local hospital environments while contributing to a shared model. We explore several established FL algorithms, assessing their suitability for training foundation models without relying on task-specific labels, conducting experiments in both homogeneous and heterogeneous settings. We evaluate the trained foundation model on three critical downstream tasks--classification, detection, and segmentation--and demonstrate that it achieves improved performance across all tasks, highlighting the effectiveness of our approach in a federated, privacy-preserving setting.
Abstract:Eye diseases are common in older Americans and can lead to decreased vision and blindness. Recent advancements in imaging technologies allow clinicians to capture high-quality images of the retinal blood vessels via Optical Coherence Tomography Angiography (OCTA), which contain vital information for diagnosing these diseases and expediting preventative measures. OCTA provides detailed vascular imaging as compared to the solely structural information obtained by common OCT imaging. Although there have been considerable studies on OCT imaging, there have been limited to no studies exploring the role of artificial intelligence (AI) and machine learning (ML) approaches for predictive modeling with OCTA images. In this paper, we explore the use of deep learning to identify eye disease in OCTA images. However, due to the lack of labeled data, the straightforward application of deep learning doesn't necessarily yield good generalization. To this end, we utilize active learning to select the most valuable subset of data to train our model. We demonstrate that active learning subset selection greatly outperforms other strategies, such as inverse frequency class weighting, random undersampling, and oversampling, by up to 49% in F1 evaluation.




Abstract:In this paper, we design a Generative Adversarial Network (GAN)-based solution for super-resolution and segmentation of optical coherence tomography (OCT) scans of the retinal layers. OCT has been identified as a non-invasive and inexpensive modality of imaging to discover potential biomarkers for the diagnosis and progress determination of neurodegenerative diseases, such as Alzheimer's Disease (AD). Current hypotheses presume the thickness of the retinal layers, which are analyzable within OCT scans, can be effective biomarkers. As a logical first step, this work concentrates on the challenging task of retinal layer segmentation and also super-resolution for higher clarity and accuracy. We propose a GAN-based segmentation model and evaluate incorporating popular networks, namely, U-Net and ResNet, in the GAN architecture with additional blocks of transposed convolution and sub-pixel convolution for the task of upscaling OCT images from low to high resolution by a factor of four. We also incorporate the Dice loss as an additional reconstruction loss term to improve the performance of this joint optimization task. Our best model configuration empirically achieved the Dice coefficient of 0.867 and mIOU of 0.765.




Abstract:Optical coherence tomography (OCT) is one of the non-invasive and easy-to-acquire biomarkers (the thickness of the retinal layers, which is detectable within OCT scans) being investigated to diagnose Alzheimer's disease (AD). This work aims to segment the OCT images automatically; however, it is a challenging task due to various issues such as the speckle noise, small target region, and unfavorable imaging conditions. In our previous work, we have proposed the multi-stage & multi-discriminatory generative adversarial network (MultiSDGAN) to translate OCT scans in high-resolution segmentation labels. In this investigation, we aim to evaluate and compare various combinations of channel and spatial attention to the MultiSDGAN architecture to extract more powerful feature maps by capturing rich contextual relationships to improve segmentation performance. Moreover, we developed and evaluated a guided mutli-stage attention framework where we incorporated a guided attention mechanism by forcing an L-1 loss between a specifically designed binary mask and the generated attention maps. Our ablation study results on the WVU-OCT data-set in five-fold cross-validation (5-CV) suggest that the proposed MultiSDGAN with a serial attention module provides the most competitive performance, and guiding the spatial attention feature maps by binary masks further improves the performance in our proposed network. Comparing the baseline model with adding the guided-attention, our results demonstrated relative improvements of 21.44% and 19.45% on the Dice coefficient and SSIM, respectively.

Abstract:In this work, we propose a Neural Architecture Search (NAS) for retinal layer segmentation in Optical Coherence Tomography (OCT) scans. We incorporate the Unet architecture in the NAS framework as its backbone for the segmentation of the retinal layers in our collected and pre-processed OCT image dataset. At the pre-processing stage, we conduct super resolution and image processing techniques on the raw OCT scans to improve the quality of the raw images. For our search strategy, different primitive operations are suggested to find the down- & up-sampling cell blocks, and the binary gate method is applied to make the search strategy practical for the task in hand. We empirically evaluated our method on our in-house OCT dataset. The experimental results demonstrate that the self-adapting NAS-Unet architecture substantially outperformed the competitive human-designed architecture by achieving 95.4% in mean Intersection over Union metric and 78.7% in Dice similarity coefficient.